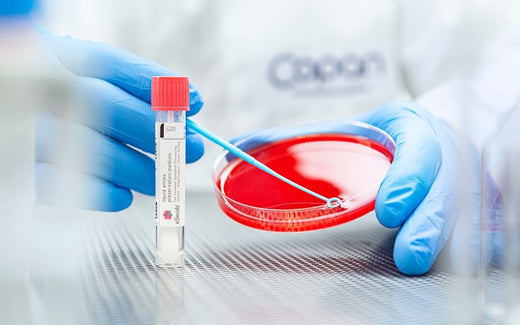
Assessing Copan ESwab™ for Nontuberculous Mycobacteria Viability in Skin and Soft Tissue Infections

The original article was provided by Copan USA.
In the intricate realm of microbiological studies, the preservation and recovery of nontuberculous mycobacteria (NTM) play a pivotal role, especially concerning skin and soft tissue infections. This exploration delves into the effectiveness of the Copan ESwab™ collection and transport system, generously provided by Copan Diagnostics Inc.
Methodology: A Scientific Symphony
To unravel the mysteries of NTM viability, the study orchestrated viability tests in triplicate, employing ESwabs and the roll plate method, meticulously adhering to CLSI M40-A2 guidelines. The ESwabs underwent duplication, with one set basking at room temperature (20°C to 25°C) and the counterpart chilling in the refrigerator (2°C to 8°C), spanning intervals of 0, 24, and 48 hours before processing.
Five chosen mycobacterial isolates, including the formidable Mycobacterium abscessus, M. fortuitum, M. chelonae, M. marinum, and M. haemophilum, took center stage. Planted on Columbia blood agar plates, these microorganisms danced to the rhythm of incubation at 30°C in an oxygen-rich environment for 5 to 7 days. Post-incubation, they gracefully transformed into 0.5 McFarland suspensions, underwent serial dilutions, and embraced the ESwabs.
Immersed in the organism suspension and tucked into corresponding ESwab tubes, the swabs embarked on their journey for colony counts on Middlebrook 7H10 agar or blood agar plates.
Revelations: A Glimpse into NTM Viability
The spotlight unveiled a fascinating spectacle: all five organisms emerged with countable colonies at dilutions of 10^6, 10^5, and/or 10^4. The counts, approximately ranging from 300 to 500 CFU/mL at 24 and 48 hours, stood in stark comparison to the initial counts at 0 hours.
Conclusion: Copan ESwab™: A Maestro of Mycobacterial Maintenance
The symphony of results harmonized into a resounding conclusion. The Copan ESwab collection and transport system exhibited its prowess, effectively maintaining and recovering NTM for an impressive 48 hours at both room and refrigeration temperatures.
Traditionally, routine swab collections might be deemed suboptimal for mycobacterial recovery. However, this study illuminated the high efficiency of ESwabs in the recovery of mycobacterial isolates, sparking curiosity for further investigation into the utility of ESwabs in clinically infected patients.
As the curtain falls on this scientific odyssey, the Copan ESwab™ emerges not just as a collection tool but as a maestro orchestrating the symphony of mycobacterial viability with precision and efficiency. The encore beckons, inviting researchers to delve deeper into the untapped potential of ESwabs in the quest for unraveling the secrets of NTM in clinically relevant scenarios.
Download the Original .pdf Paper Here
Date July 3, 2019
Conference or Journal Sinai Health System
Author(s) Gandh Wood Mazzulli
Categories ESwab™